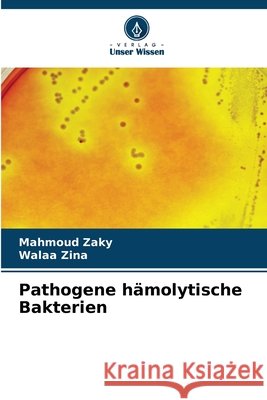
Pathogene hämolytische Bakterien Zaky, Mahmoud, Zina, Walaa 9786202362320 Verlag Unser Wissen - książka

Pathogene hämolytische Bakterien » książka
Pathogene hämolytische Bakterien
ISBN-13: 9786202362320 / Niemiecki / Miękka / 2025 / 68 str.
Die Fähigkeit von Bakterienkolonien, bei Wachstum auf Blutagar eine Hämolyse auszulösen, wird zur Klassifizierung bestimmter Mikroorganismen herangezogen. Es gibt drei Arten der Hämolyse: Alpha-, Beta- und Gamma-Hämolyse. Die Alpha-Hämolyse ist eine partielle Hämolyse und wird aufgrund der Farbveränderung des Agars als grüne Hämolyse bezeichnet. Die Beta-Hämolyse ist eine vollständige Hämolyse, bei der die roten Blutkörperchen im Medium vollständig lysieren und das Medium heller und transparenter erscheint. Die Gamma-Hämolyse ist nicht hämolytisch. Eine Substanz, die Hämolyse verursacht, ist ein Hämolysin. Hämolysine sind bestimmte Proteine und Lipide, die durch Schädigung der Zellmembran eine Lyse der roten Blutkörperchen verursachen. Obwohl Hämolysine in vitro rote Blutkörperchen lysieren können, ist die Fähigkeit von Hämolysinen, andere Zellen, einschließlich weißer Blutkörperchen, anzugreifen, oft für die Wirkung von Hämolysinen während einer Infektion verantwortlich. Pathogene hämolytische Bakterien können grampositive Bakterien wie (Staphylococcus, Streptococcus, Bacillus und Listeria) oder gramnegative Bakterien wie (Neisseria, Pseudomonas, Haemophilus, Helicobacter, Escherichi, Klebsiella, Salmonella, Shigella und Proteus) sein. Untersuchen Sie die allgemeinen Eigenschaften jeder Bakterie, die beim Menschen Krankheiten verursacht.